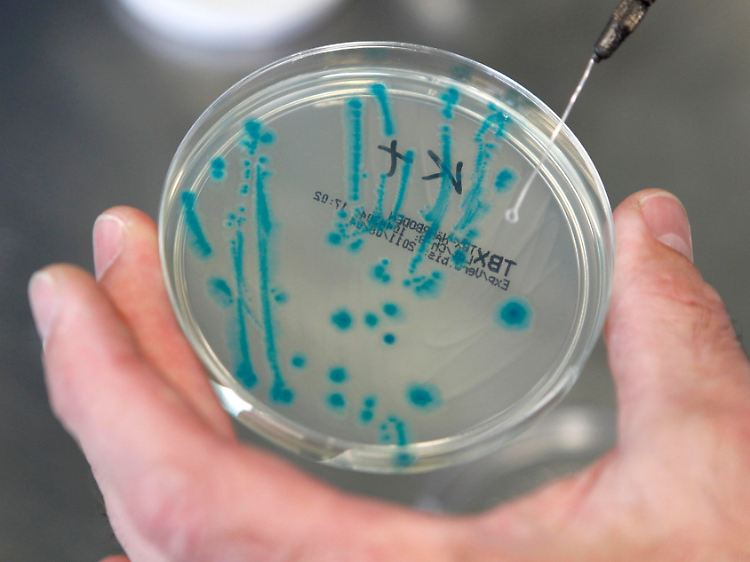

Jetzt 29 EHEC-Tote in Deutschland Biohof darf wieder verkaufen
09.06.2011, 20:06 Uhr
Gegen den verdächtigten Biohof in Bienenbüttel liegen keine Beweise vor.
(Foto: dapd)
Die Zahl der EHEC-Neuerkrankungen in besonders betroffenen Bundesländern geht zurück. Gurken, Tomaten, Salat und Sprossen gelten weiter als verdächtig, den gefährlichen Darmkeim übertragen zu haben. Gegen den unter EHEC-Verdacht stehenden Biohof in Bienenbüttel gibt es keine Beweise, er darf außer Sprossen weiterhin anderes Gemüse verkaufen. Kanzlerin Merkel ist mit dem Krisenmanagement zufrieden.
Die EHEC-Epidemie in Deutschland schwächt sich ab. Auch wenn Mediziner noch keine Entwarnung geben - die Zahl der Neuerkrankungen in den besonders betroffenen Bundesländern wie Niedersachsen und Hamburg nimmt ab. Inzwischen sind laut offiziellen Angaben 29 Menschen nach einer EHEC-Infektion gestorben. Der 29. Tote wurde aus Hessen gemeldet.
Bundeskanzlerin Angela Merkel (CDU) lobte das Krisenmanagement. Die Zusammenarbeit zwischen den Stellen in Bund und Ländern sei gut, sagte sie nach einem Treffen mit den Ministerpräsidenten in Berlin. Sie habe keinen Zweifel, dass an der komplizierten Suche nach der Quelle des Darmkeims mit Nachdruck gearbeitet werde. Wissenschaftler versuchen jetzt, mit Proben von Gurken und Gemüsesprossen die Infektionsquelle aufzuspüren - ohne Erfolg. Weiterhin gelten Sprossen, Salat, Tomaten und Gurken als mögliche Träger des Bakteriums.
Im Bundesinstitut für Risikobewertung (BfR) brachten Untersuchungen von EHEC-verseuchten Gurkenproben aus Magdeburg noch keine neuen Hinweise. Die Gurkenreste waren am Mittwoch in einer Mülltonne in Magdeburg gefunden worden. Die Tonne gehört einer Familie, die an EHEC erkrankte. Das Berliner BfR-Labor untersucht nun, ob es sich bei dem gefundenen Erreger um denselben aggressiven Typ O104:H4 handelt, der als Auslöser der aktuellen EHEC-Welle gilt.
Biohof darf wieder verkaufen
Eine der wenigen Spuren, die Wissenschaftler nach wie vor für erfolgsversprechend halten, sind Proben von Sprossengemüse von einem Betrieb im Kreis Uelzen in Niedersachsen. "Es läuft alles auf diesen Betrieb hinaus, es läuft alles auf Sprossen hinaus", sagte der Sprecher des Landwirtschaftsministeriums in Hannover, Gert Hahne. Doch fehle weiterhin der Labornachweis. Der verdächtigte Biohof in Bienenbüttel darf außer Sprossen weiterhin anderes Gemüse wie Tomaten und Gurken verkaufen. "Wir haben nur Hinweise auf Sprossen", sagte Hahne. Für eine Sperrung müsse man Beweise haben.
Die Chance, die EHEC-Epidemie aufzuklären, ist nicht groß. Nach BfR-Angaben konnte in der Vergangenheit nur ein Viertel der EHEC-Ausbrüche in Deutschland bis zur Quelle des Erregers zurückverfolgt werden. Hauptgrund: verdächtigte Lebensmittel sind zum Zeitpunkt der Erkrankungen meist restlos verbraucht.
Spanien lenkt ein
Spanien will auf Schadenersatzklagen gegen Deutschland verzichten. Auf mögliche private, rechtliche Forderungen der Bauern gegen den Hamburger Senat habe die Regierung aber keinen Einfluss, sagte Spaniens Europaminister Diego Lopez Garrido in Berlin. Zur Warnung des Hamburger Senats vor Gurken aus Spanien sagte er: "Es wurden Fehler gemacht." Nach Deutschland gehe etwa ein Viertel aller Gemüseexporte.
Der Ministerpräsident der südspanischen Region Andalusien, José Antonio Griñán, warnte davor, in einen "Deutschen-Hass" zu verfallen. Die Deutschen seien die wichtigsten Kunden andalusischer Landwirte. Auch Gemüsebauern in Südspanien hatten Millionenverluste erlitten. Die unter der EHEC-Krise leidenden Bauern sollen nach dem Willen der EU-Kommission höher entschädigt werden als geplant: 210 Millionen Euro statt der zunächst vorgeschlagenen 150 Millionen Euro. Die EU-Staaten müssen dem noch zustimmen.
EHEC bremst Ruder-Weltcup aus
Aus Angst vor der EHEC-Epidemie hat die britische Ruder-Nationalmannschaft ihre Teilnahme am Weltcup in Hamburg abgesagt. Der Weltcup findet vom 17. bis 19. Juni in der Hansestadt statt. Die Absage erfolgte, obwohl der Weltruderverband FISA in Abstimmung mit dem Ausrichter und der Hamburger Gesundheitsbehörde keinen Anlass sieht, die Veranstaltung abzusagen. Die Briten ließen sich jedoch nicht umstimmen.
Quelle: ntv.de, dpa/AFP/rts